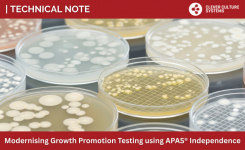
Technical Note - Modernise Your Growth Promotion Testing with APAS Independence

With regulatory bodies driving an increasing focus on environmental monitoring (EM) and contamination control strategy (CCS), pharmaceutical quality control programs are turning to alternative microbiological methods to improve processes, seeking to improve quality of results as well as achieve operational efficiencies. Innovative products featuring new technologies, such as artificial intelligence (AI), are emerging to help address these challenges. Understanding how the products are developed, the data used, and performance is critical for the implementation of these technologies into routine use.
Explore how AI-powered automation technology, like the APAS® Independence, is empowering EM programs to increase throughput, reduce operator subjectivity, and uphold regulatory compliance.
In this on-demand webinar, gain perspective into:
- How Annex 1 has increased awareness of the importance of EM and the extent of testing required for an effective CCS
- The importance of AI governance and data management through the lifecycle of product development
- The ISPE AI Maturity Model and how automated systems should be considered in terms of risk
- Regulatory expectations for performance, data integrity, and traceability in EM plate reading
- Real-world insights, including evaluation approaches and validation data from pharma partners
Presented by: Steven Giglio, PhD, Chief Scientific Officer, Clever Culture Systems
Dr Steven Giglio has 30 years’ experience in microbiology applications and has been instrumental in the development of new and rapid technologies. He has led several large laboratories and has guided the implementation of automation systems and workflows globally. At Clever Culture Systems, Steven is responsible for the development of artificial intelligence models for culture plate reading and interpretation, as well as representing the company as a domain expert in professional forums.